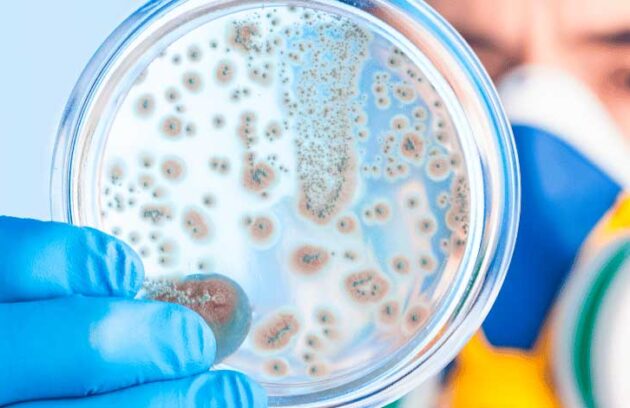
spx-clinica-spx-imagem-propagacao-de-superbacterias

A tecnologia genômica e a Inteligência Artificial podem ajudar a combater a propagação das superbactérias, segundo pesquisadores
Farmacêuticas têm investido em medicamentos para o câncer a fim de fornecer tratamentos inovadores com anticorpos específicos
Cientistas revelam o maior avanço, em 20 anos, no tratamento com um novo medicamento para câncer de colo de útero
Veja um comparativo feito entre o ChatGPT e os médicos no que remete ao tratamento e orientação sobre a depressão
Após estudo realizado em Harvard (EUA), descubra como a tecnologia pode salvar vidas ao simular funções dos órgãos humanos
Você sabia que a doença falciforme em crianças está associada à dores e distúrbios do sono? Saiba o que um…
Segundo estudo realizado, o diagnóstico de bipolaridade pode ser identificado após um teste sanguíneo. Saiba mais!
Uma revista científica foi capaz de apontar a semelhança entre fungos no cérebro e sintomas de alzheimer após testes envolvendo…
Chamado de Onco-PDO, esse exame que recria tumor em 3D permite aos médicos testar o melhor tratamento a partir de…
O SenseToKnow utiliza inteligência artificial e é um aplicativo que pode diagnosticar autismo em crianças de até três anos